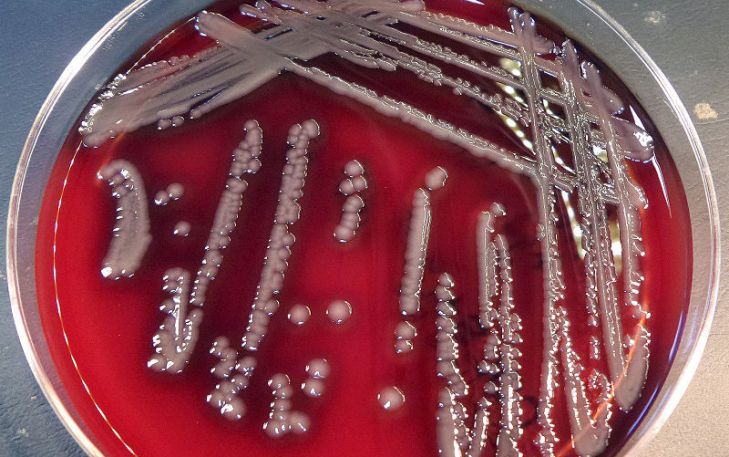
бактерии Aeromonas hydrophila

Специалисты исследовали токсин аеролизин, который производится гетеротрофной бактерией Aeromonas hydrophila.
Из токсина учёные сделали биосенсор, сообщают интернет-источники.
Добиться этого удалось за счёт узких пор в веществе, с помощью которых можно с высокой точностью различать молекулы.
Структурная модель токсина была создана с использованием компьютерных технологий.
В ходе эксперимента исследователи производили замену аминокислот в белке и наблюдали, как изменения влияли на проводимость и структуру вещества.
После этого в поры был встроен двойной фосфолипидный слой, напоминающий клеточную мембрану.
Исследование доказало важность электростатического взаимодействия и размера пор для превращения аеролизина в биосенсор.
Фото: из открытых источников












